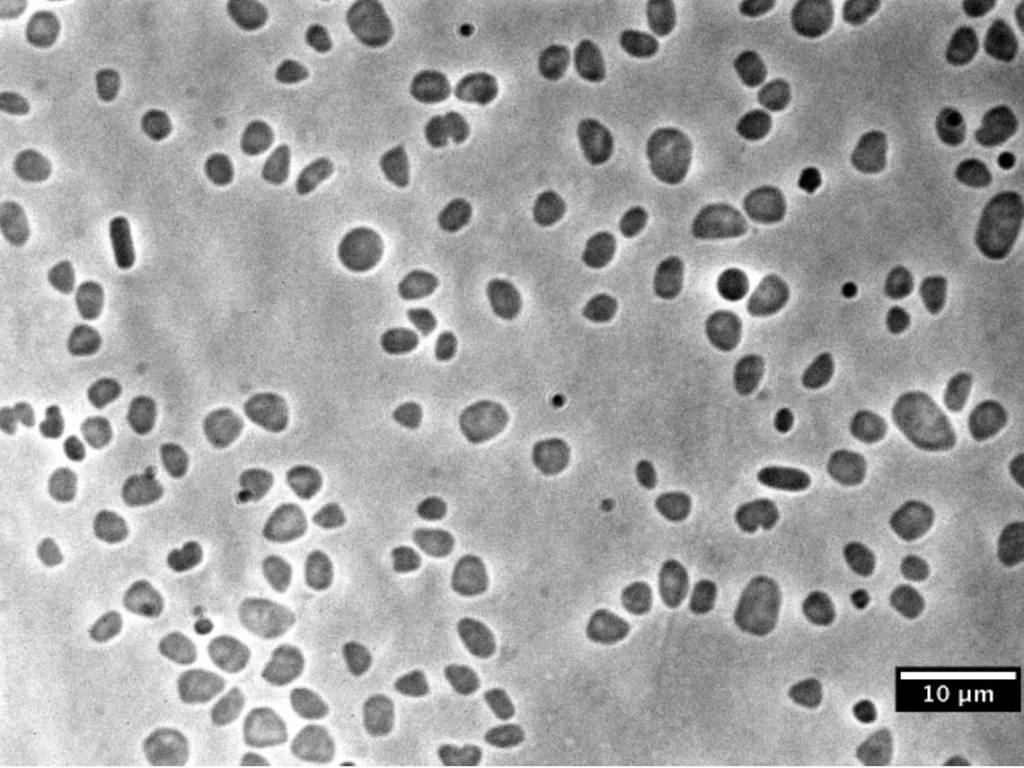

Nos fascina todo lo que sea muy diferente a nosotros, como los organismos que crecen en ambientes donde nos serían inviable salir adelante de forma natural. Entornos donde se pensaba, hasta hace no mucho tiempo, que ni podría haber vida.
Los extremófilos (el sufijo "-filo" proviene del griego φιλíα, amor) tienen "amor" por los entornos extremos. Son, en su mayoría, microorganismos de los dominios de las bacterias y las arqueas, aunque también hay algas, hongos y pequeños animales.
Entre sus poderes, pueden resistir: alta radiación (radiófilos), alta presión (barófilos), alto o bajo pH (alcalófilos y acidófilos), calor extremo (termófilos), frío extremo (psicrófilos), sequía extrema (xerófilos) y altas concentraciones de sal (halófilos).
Condiciones que, para nosotros, serían un verdadero infierno.
Para hacer frente a estos ambientes "poco apacibles", los extremófilos desarrollaron componentes celulares (como enzimas y membranas) adaptados para operar donde pocos pueden.
Ahora sí, conozcamos más de cerca a 5 de ellos.
Tardígrados. Supervivientes todoterreno

Los tardígrados, popularmente conocidos como osos de agua, tenían que encabezar esta lista, y ocupar un lugar especial en ella. Su nombre alude a su paso lento, como si fueran osos perezosos, pero de ocho patas en vez de cuatro.
Estos pequeños invertebrados alcanzan de adultos el medio milímetro, en el caso de los especímenes más grandes, y se encuentran en casi todas partes. Abundan en hábitats tanto terrestres (en los musgos y líquenes), como acuáticos (de agua dulce y salada).
Se conocen más de 1.200 especies, y pueden sobrevivir en ambientes muy diversos, resistiendo más de una condición extrema. Por eso se consideran poliextremófilos.
Cuando las cosas se ponen difíciles (frío y sequedad extremos, por ejemplo), entran en un estado llamado criptobiosis, en el que su actividad vital se vuelve casi indetectable. Reducen su metabolismo, cesa su crecimiento y dejan de reproducirse. De ese modo pueden permanecer años, hasta que las cosas mejoren.
Por si fuera poco, resisten presiones atmosféricas enormes, altas temperaturas, radiación ionizante y hasta la exposición al espacio exterior, tal y como se demostró en 2007. El experimento se llevó a cabo dentro de la plataforma experimental Biopan- 6 de la Agencia Espacial Europea, durante la misión FOTON-M3.
El vacío (que impone una deshidratación extrema) y la radiación cósmica impiden la supervivencia en el espacio de la mayoría de los organismos. Los tardígrados, que se dieron su pequeño paseo espacial, son una de las pocas excepciones.
Haloferax volcanii. ¡Hasta arriba de sal!
Haloferax volcanii es una arquea perteneciente al filo Euryarchaea. Fue aislada por Benjamin Volcani (de ahí su nombre) entre los sedimentos del Mar Muerto, uno de los lagos más salados del mundo, en 1970.
Su punto fuerte es, claro está, que aguanta la sal de maravilla, por lo que se clasifica dentro del grupo de las haloarqueas.
Y no es solo que resista la gran concentración salina, sino que la necesita para vivir. Evolutivamente, se ha adaptado a los entornos salinos modificando su concentración salina intracelular. La temperatura óptima a la que se desarrolla es de 45 °C. Así que la receta para su hogar ideal es: agua caliente y muy salada. Algo así como vivir en una sopa.
Pyrococcus furiosus. Caliente, caliente

Este arquea ama el calor. Tanto que se pertenece al grupo de los hipertermófilos. Su temperatura óptima de crecimiento se sitúa cerca de los 100 °C. Fue aislada por primera vez en los lodos situados junto a la playa Porto di Levante, en la isla Vulcano (Italia).
Su nombre científico, traducido, sería algo así: "bola de fuego veloz". Veloz porque se reproduce muy rápido (en 37 minutos) y porque puede moverse ágilmente gracias a sus flagelos; bola de fuego, por su forma de coco y su amor a las altas temperaturas.
Thermococcus gammatolerans. Soportando la radiación

Se trata de otro extremófilo que resiste altas temperaturas, pero su gran punto fuerte es la radiorresistencia. Además de desarrollarse perfectamente a unos 90 °C, la Thermococcus gammatolerans aguanta como nadie las radiaciones ionizantes (las más peligrosas a dosis altas). Es capaz de soportar 10 veces la cantidad de radiación que mataría a un ser humano.
Fue hallada en 2003, en las fuentes hidrotermales subacuáticas de la Cuenca de Guaymas (Golfo de California), a unos 2.000 metros de profundidad.
Este arquea abre un interesante campo de investigación sobre la fisiología de la radiorresistencia, de gran utilidad para averiguar cómo se reparan los cromosomas dañados después de la exposición a la radiación.
Helicobacter pylori. La extrema acidez es su hogar

Como no todos van a ser organismos de lugares remotos, aquí tenemos a una vecina común de nuestras tripas, cuyos poderes acidófilos nos traen algún que otro disgusto.
Esta bacteria gramnegativa, que debe el nombre a su forma helicoidal, vive en el ambiente extremadamente ácido del estómago (con un pH en torno a 3,5). Para protegerse del ácido clorhídrico del estómago, secreta una enzima llamada ureasa.
Se estima que dos terceras partes de la población del mundo se encuentran infectadas por la bacteria, aunque un gran porcentaje no muestra síntomas.
La bacteria lleva con nosotros miles de años. Es la causante de inflamaciones de la mucosa gástrica, que pueden conducir a gastritis y úlceras, y predisponer a ciertos tipos de cáncer.
¿Extremófilos fuera de nuestro planeta?
La disciplina que se encarga de investigar sobre las posibilidades de vida extraterrestre, la exobiología, se beneficia del estudio de estos microorganismos.
¿Podrían sobrevivir nuestros extremófilos terrestres en otros planetas y sus satélites? Posiblemente. Los halopsicrófilos (resistentes al frío y a la concentración salina) que mejor toleraran las altas presiones, podrían subsistir en Titán, Ceres y Europa, que probablemente tengan océanos salinos bajo su superficie.
Las nubes de Venus, con grandes variaciones de temperatura, podrían permitir la existencia de microorganismos termoacidófilos o psicroacidófilos (resistentes al calor y la acidez, y al frío y la acidez, respectivamente).
Nos queda mucho por saber acerca de las posibilidades de la vida fuera de nuestro planeta. Pero, desde luego, los extremófilos nos enseñan que lo que para nosotros es inhóspito, para otras formas de vida es idóneo.
Quizá lo extremo no sea tan raro. Al fin y al cabo, si consideramos que las condiciones actuales de la Tierra (su temperatura media, su atmósfera oxigenada, etc.) representan un corto período de tiempo desde que existe la vida, podríamos concluir que las formas de vida extremófilas han sido las dominantes a lo largo de la evolución.
Referencias:
Delgado Romero, J. A. (2021) 'Microorganismos extremófilos. Vida microbiana más allá de sus condiciones óptimas', Universidad de Sevilla
Jolivet, E., et al. (2003) 'Thermococcus gammatolerans sp. nov., a hyperthermophilic archaeon from a deep-sea hydrothermal vent that resists ionizing radiation', International Journal of Systematic and Evolutionary Microbiology, 53(3), 847-851
Merino, N., et al. (2019) 'Living at the extremes: extremophiles and the limits of life in a planetary context', Frontiers in microbiology, 10, 780. DOI: 10.3389/fmicb.2019.00780
Sjomina, O. et al. (2018) 'Epidemiology of Helicobacter pylori infection', Helicobacter, 23, e12514. DOI: 10.1111/hel.12514C
Sohl, F. et al. (2010) 'Subsurface water oceans on icy satellites: Chemical composition and exchange processes', Space Science Reviews, 153(1), 485-510. DOI: 10.1007/s11214-010-9646-y




